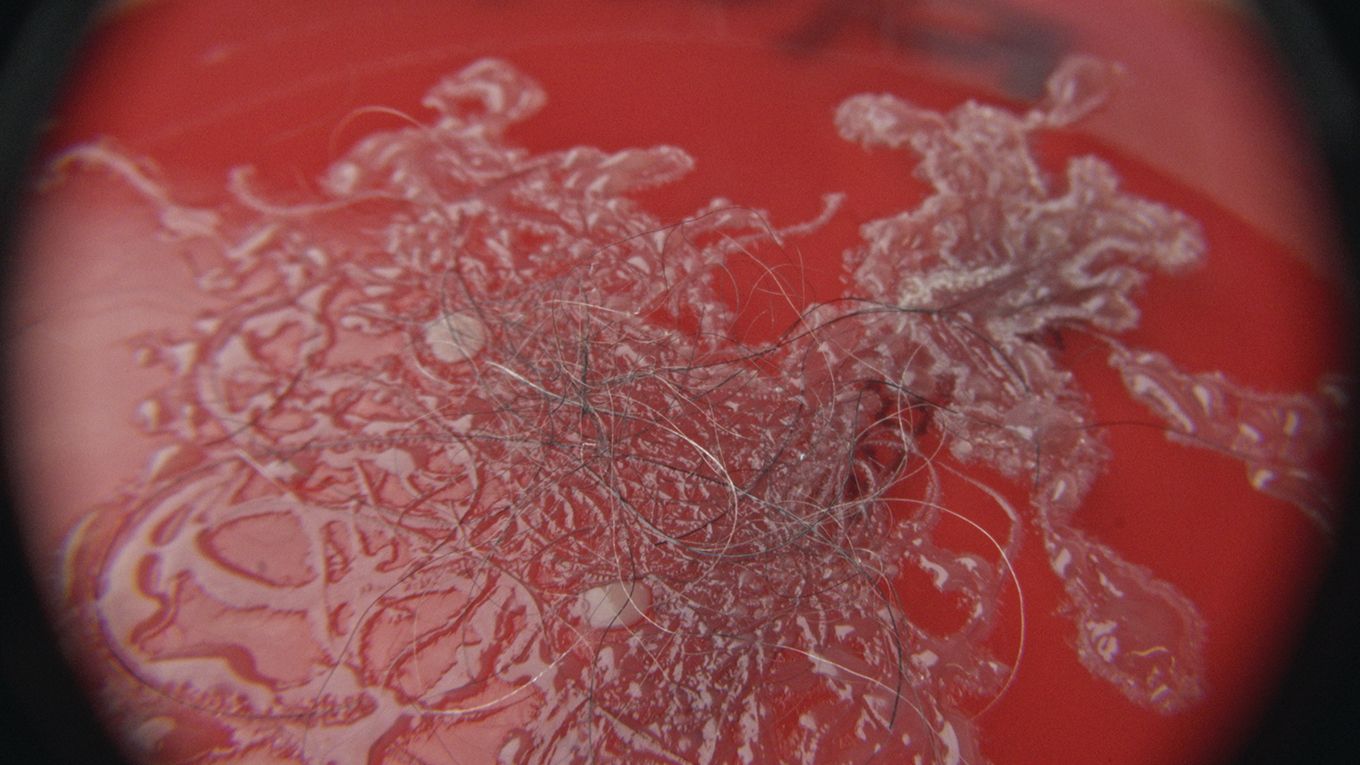
Tierhaare unter Mikroskop

Staubsauger für Tierhaare
Haustiere bringen viel Freude in unser Leben aber auch jede Menge Schmutz. Haustierbesitzer finden in allen Ecken hartnäckige Tierhaare. Mit herkömmlichen Staubsaugern lassen diese sich oft nicht entfernen. Erfahre, worauf es bei Tierhaarstaubsaugern ankommt und wie Dyson Staubsauger Tierhaare, Hautpartikel und Gerüche zuverlässig entfernen.

-
Nimmt Tierhaare auf
Befördert lose Haare direkt in den Staubsauger, während du dein Haustier bürstest.
-
Schnelle und komfortable Fellpflege
364 Borsten, die in einem Winkel von 35° angebracht sind, nehmen während des Bürstens eine aufrechte Position ein.
-
Entfernt Allergene
Die Bürste nimmt bei jedem Durchgang abgestorbene Hautschuppen auf und verhindert, dass sich diese in deinem Zuhause ausbreiten.
Dyson reinigt Tierhaare gründlich an jeder Stelle
Warum Tierhaarstaubsauger wichtig sind
Tierhaare sind besonders schwer zu entfernen. Das liegt daran, dass sie sehr fein sind und ein Drittel kleiner sein können als menschliche Haare. Auch aufgrund ihrer Fette haften Tierhaaren an unterschiedlichsten Oberflächen. Vor allem von Wollfasern, wie beispielsweise Polstermöbel oder Teppichen, sind sie schwer zu beseitigen. Einfacher ist es, glatte Oberflächen von Tierhaaren zu befreien. Allerdings begünstigt die elektrostatische Aufladung wieder deren Haftung.
Hier können Dyson Staubsauger für Hundehaare und Katzenhaare für Abhilfe sorgen. Unsere Tierhaarstaubsauger sind nicht allein auf die Entfernung von Haaren ausgelegt. Unsere Geräte entfernen auch mikroskopisch kleine Partikel, wie Bakterien und Allergene, die Haustiere möglicherweise ins Haus tragen und dort verbreiten. Der fortschrittliche HEPA-Filter sorgt anschließend dafür, dass die Partikel zuverlässig im Gerät eingeschlossen bleiben und Gerüche entfernt werden. Für mehr Flexibilität können unsere kabellosen Staubsauger mit wenigen Handgriffen in einen Handstaubsauger umgewandelt werden. Dies sorgt für komfortableres Reinigen. Außerdem sind unsere Staubsauger für Tierhaare leise, sodass sie nicht nur dein eigenes, sondern auch das empfindliche Gehör deines vierbeinigen Familienmitglieds schonen.
Diese Spuren entfernen Tierhaarstaubsauger
Tierhaare
Tierhaare sind sichtbar doch die Partikel wie z.B. Schmutz, die an den Haaren festhaften, sind wiederum oft unsichtbar.
Hautpartikel
Diese Allergene setzen sich aus getrockneten Hautschuppen und Speichel zusammen. Gelangen sie in die Luft, können sie sich auf Möbeln, Bettzeug und mehr ansiedeln.
Bakterien
Schmutz aus dem Freien kann an Tierhaaren haften und die Ausbreitung von Bakterien in deinem Zuhause begünstigen.
Pollen
Durch die Pfoten und Haare deines Haustieres können Pollen in dein Zuhause gelangen und sich ausbreiten.
-
Dyson Staubsauger entfernen Tierhaare auf allen Oberflächen
Dyson Tierhaarstaubsauger machen dank der Bodendüse mit Lichtstrahl schwer erkennbare Haare sichtbar. Feste Nylonborsten der Motorbar™ Bodendüse dringen tief in Teppiche ein, um sogar hartnäckige Tierhaare zu entfernen. Auch auf Hartböden entfernen antistatische Carbonfaser Filamente Staub, Hautpartikel und Haare verlässlich.
-
Unsere Tierhaarstaubsauger entwirren Haare automatisch
Die Bürstwalze der Haardüse verläuft konisch, um die Haare in den Staubbehälter zu transportieren. Die Lamellen aus Polycarbonat wickeln verfangene Tierhaare, die sich tief in den Borsten festgesetzt haben, von der Bürstwalze. Indem sie das Haar ans Ende transportieren, kann es anschließend einfach entfernt werden. Die Bürstwalze ist abnehmbar und waschbar für eine einfache Wartung.
-
Dyson Tierhaarstaubsauger schließen Partikel ein
Das hocheffiziente Filtersystem von Dyson schließt 99,99 % der bis zu 0,3 Mikron kleinen Partikel ein. Unsere HEPA-Staubsauger bieten eine Filtrationseffizienz von 99,97 % bei Partikeln mit einer Größe von bis zu 0,1 Mikron.* Was in den Staubsauger gelangt, bleibt dort auch. Somit werden auch Gerüche entfernt.
Weitere Tipps zum Entfernen von Tierhaaren
Tipp 1: Es empfiehlt sich, regelmäßig Düse, Rohr und Schlauch des Staubsaugers auf Haarknäuel zu untersuchen und diese zu entfernen.
Tipp 2: Mit einem Mikrofasertuch entfernst du Tierhaare auch an Stellen, die für Staubsauger schwer zu erreichen sind. Mikrofasern laden sich elektrostatisch auf und können Haare so gut binden.
Tipp 3: Mit einem feuchten Tuch lassen sich Tierhaare gut entfernen. Ziehe das Tuch über die Polster, sodass die Haare daran hängen bleiben.
Tipp 4: Damit dein Tierhaarstaubsauger keine unangenehmen Gerüche annimmt, solltest du den Behälter regelmäßig entleeren, gründlichen reinigen und rechtzeitig verschleißempfindliche Teile wechseln, wie z. B. den HEPA-Filter.
Tipp 5: Um zu vermeiden, dass Tierhaare dein Zuhause verschmutzen, solltest du dein Haustier regelmäßig bürsten – vor allem während des Fellwechsels. So kannst du die Menge an Tierhaaren minimieren, die auf Böden und Möbeln landet.
Tipp 6: Sollten Hautpartikel und Haare allergische Reaktionen bei dir oder deinen Gästen auslösen und ein Staubsauger Tierhaare allein nicht ausreichend beseitigen, ist ein Raumklimagerät eine weitere Option.
Häufige Fragen zu Tierhaarstaubsaugern
Wir empfehlen, die am häufigsten genutzten Bereiche, wie Hartböden oder Teppiche, täglich abzusaugen. Insbesondere während des Fellwechsels solltest du mindestens einmal am Tag staubsaugen. Polstermöbel und Betten solltest du ein- bis viermal pro Woche saugen. Häufiger, wenn du mehrere Haustiere hast, um eine starke Verschmutzung zu vermeiden und dein Zuhause sauber zu halten.
Achte auf Modelle mit hoher Saugleistung, speziellen Bürsten und Zubehör für Tierhaare. Beutellose Staubsauger können genauso effektiv bei der Entfernung von Tierhaaren sein wie Staubsauger mit Beutel.